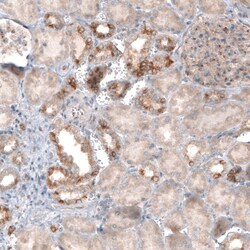

Antibody data
- Antibody Data
- Antigen structure
- References [0]
- Comments [0]
- Validations
- Immunohistochemistry [4]
Submit
Validation data
Reference
Comment
Report error
- Product number
- MA5-31404 - Provider product page

- Provider
- Invitrogen Antibodies
- Product name
- CLIP1 Monoclonal Antibody (CL4844)
- Antibody type
- Monoclonal
- Antigen
- Recombinant full-length protein
- Description
- Immunogen sequence: KNLELQLKEN KRQLSSSSGN TDTQADEDER AQESQIDFLN SVIVDLQRKN QDLKMKVEMM SEAALNGNGD DLNNYDSDDQ EKQSKKKPRL FCDICDCFDL HDTEDCPTQA QMSEDPPHST HHGSRGEERP YCEICEMFGH WATNCNDDET
- Reactivity
- Human
- Host
- Mouse
- Isotype
- IgG
- Antibody clone number
- CL4844
- Vial size
- 100 μL
- Concentration
- 1 mg/mL
- Storage
- Store at 4°C short term. For long term storage, store at -20°C, avoiding freeze/thaw cycles.
No comments: Submit comment
Supportive validation
- Submitted by
- Invitrogen Antibodies (provider)
- Main image

- Experimental details
- Immunohistochemical analysis of CLIP1 in human cervix using CLIP1 Monoclonal Antibody (CL4844) (Product # MA5-31404) shows moderate cytoplasmic positivity in squamous epithelial cells.
- Submitted by
- Invitrogen Antibodies (provider)
- Main image
- Experimental details
- Immunohistochemical analysis of CLIP1 in human kidney using CLIP1 Monoclonal Antibody (CL4844) (Product # MA5-31404) shows moderate cytoplasmic immunoreactivity in a subset of renal tubules.
- Submitted by
- Invitrogen Antibodies (provider)
- Main image

- Experimental details
- Immunohistochemical analysis of CLIP1 in human prostate using CLIP1 Monoclonal Antibody (CL4844) (Product # MA5-31404) shows weak cytoplasmic positivity in glandular and smooth muscle cells.
- Submitted by
- Invitrogen Antibodies (provider)
- Main image

- Experimental details
- Immunohistochemical analysis of CLIP1 in human placenta using CLIP1 Monoclonal Antibody (CL4844) (Product # MA5-31404) shows strong cytoplasmic immunoreactivity in trophoblast.
 Explore
Explore Validate
Validate Learn
Learn Western blot
Western blot Immunohistochemistry
Immunohistochemistry